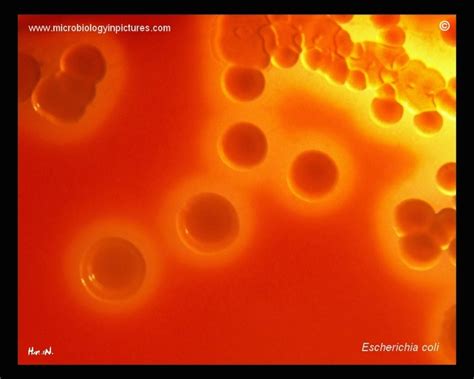
escherichia coli hemolysis  blood  beta hemolytic colonies

Jika kamu sedang mencari Hemolytic Bacteria, maka anda berada di halaman yang tepat. Kami menyediakan aneka Hemolytic Bacteria yang bisa anda pesan online. Silakan hubungi kami via +6282245078486, jangan lupa sertakan juka gambar yang diinginkan.
Kami mengirim paket Hemolytic Bacteria melalui berbagai ekspedisi, misalnya JNE, JNT, POS, dll. Kami juga menerima pembayaran via BCA/Mandiri/dll. Pengiriman biasanya tidak sampai seminggu sudah sampai dan kami sertakan pula nomor resi yang bisa digunakan untuk tracking barang secara online.

Tidak hanya Hemolytic Bacteria, anda juga bisa melihat gambar lain seperti
Alpha Beta,
Blood Agar,
Alpha Beta Gamma,
Alpha,
Beta,
List »Beta,
Chart,
Gram-positive Beta,
Gram-negative Beta,
Activity,
Patterned,
Flowchart,
Streptococcus Pyogenes,
Streptococcus Pneumoniae,
Moraxella Catarrhalis,
Group B Streptococcus,
Pathogenic Bacteria,
and Hemolytic Anemia.
Berbagai Contoh Hemolytic Bacteria
Berikut kami sertakan berbagai contoh gambar untuk Hemolytic Bacteria, silakan save gambar di bawah dengan klik tombol pesan, anda akan kami arahkan pemesanan via WA ke +6282245078486.
 1600×1323
1600×1323
experimenter watching hemolytic bacteria stock image image heap
Order Sekarang
 640×640
640×640
measurement hemolytic bacteria human saliva ab percentages
Order Sekarang
 1024×789
1024×789
experimenter watching hemolytic bacteria plates stock photo
Order Sekarang
 1600×1156
1600×1156
streptococcus bacterial colonies alpha hemolytic blood
Order Sekarang
 1430×1078
1430×1078
alpha beta hemolytic streptococcus red mountain microbiology
Order Sekarang
 0 x 0
0 x 0
alpha beta hemolytic strep overview treatment lesson studycom
Order Sekarang
 850×287
850×287
hemolytic activity bacillus strains legend negative control
Order Sekarang
 1000×776
1000×776
streptococcus bacterial colonies beta hemolytic blood
Order Sekarang
 650×520
650×520
group streptococcusgbs sagalactiae beta hemolytic group
Order Sekarang
800×640
800×640
escherichia coli hemolysis blood beta hemolytic colonies
Order Sekarang
 1024×768
1024×768
gram positive bacteria clinical case studies ii powerpoint
Order Sekarang
 750×358
750×358
perfect pathogen storm deadly bacteria adapting plastic
Order Sekarang
 1000×685
1000×685
hemolysis bacterial colonies induce hemolysis grown blood
Order Sekarang
 1000×800
1000×800
moment harmless bacteria turns flesh eating killer recorded
Order Sekarang
 0 x 0
0 x 0
streptococcus pathogenesis classification alpha hemolytic
Order Sekarang
 0 x 0
0 x 0
bacterial hemolysis types hemolysis microbiology akash
Order Sekarang
 1440×1800
1440×1800
microbiologygram studying hemolysis patterns blood
Order Sekarang
 736×552
736×552
ghim cua aaron mclaughlin tren medical laboratory science
Order Sekarang
Temukan solusi terbaik untuk kenyamanan ruang Anda dengan Hemolytic Bacteria! Produk peredam suara dan panas ini menawarkan performa maksimal dengan harga yang terjangkau. Dapatkan kualitas unggul tanpa menguras kantong, dan nikmati suasana tenang serta sejuk di setiap sudut rumah atau kantor Anda. Pilih Hemolytic Bacteria – pilihan cerdas untuk investasi jangka panjang!
Maaf, tidak ada yang cocok dengan kriteria yang Anda cari.
Apa yang ingin Anda lakukan?
« kembali ke Beranda atau gunakan kotak pencarian dibawah ini untuk mulai penelusuran baru.










